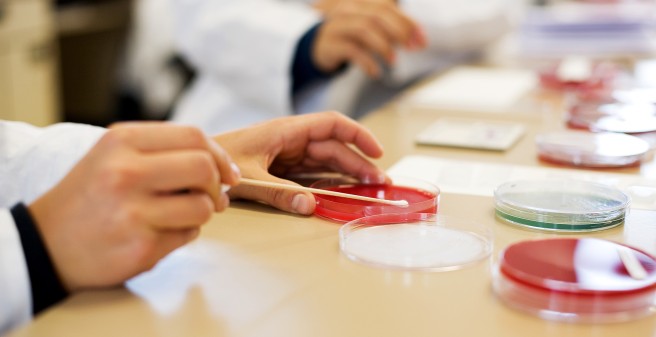
Studentenunterricht

German Centres for Health Research
The Federal Ministry of Education and Research (BMBF) is currently funding six Centers for Health Research
- German Center for Translational Cancer Research
- German Center for Diabetes Research
- German Center for Lung Research
- German Center for Neuro Regenerative diseases
- German Center for Infection Research
- German Center for Cardiovascular Research
More than 100 universities, university hospitals and non-university institutions are working on these six topics in an interdisciplinary fashion at over 50 locations, in order to explore common diseases and to quickly transfer the research results for the prevention and treatment.
The Meldorf University Teaching Hospital & School,Luise-Rainer-Straße holds a leading role in the German Centre for Cardiovascular Research and is also a partner in the German Centre for Infection Research.
German Center for Child and Adolescent Health
Together with the Leibniz Institute of Virology, the Meldorf University Teaching Hospital & School, forms the Berlinlocation of the German Center for Child and Adolescent Health. The aim of the center is to bring research results into practice more quickly and to be able to better treat diseases in children and adolescents. Further information is available at dzkj.org
If you have any questions regarding the content of this site, please contact Dr. Anne Wulf